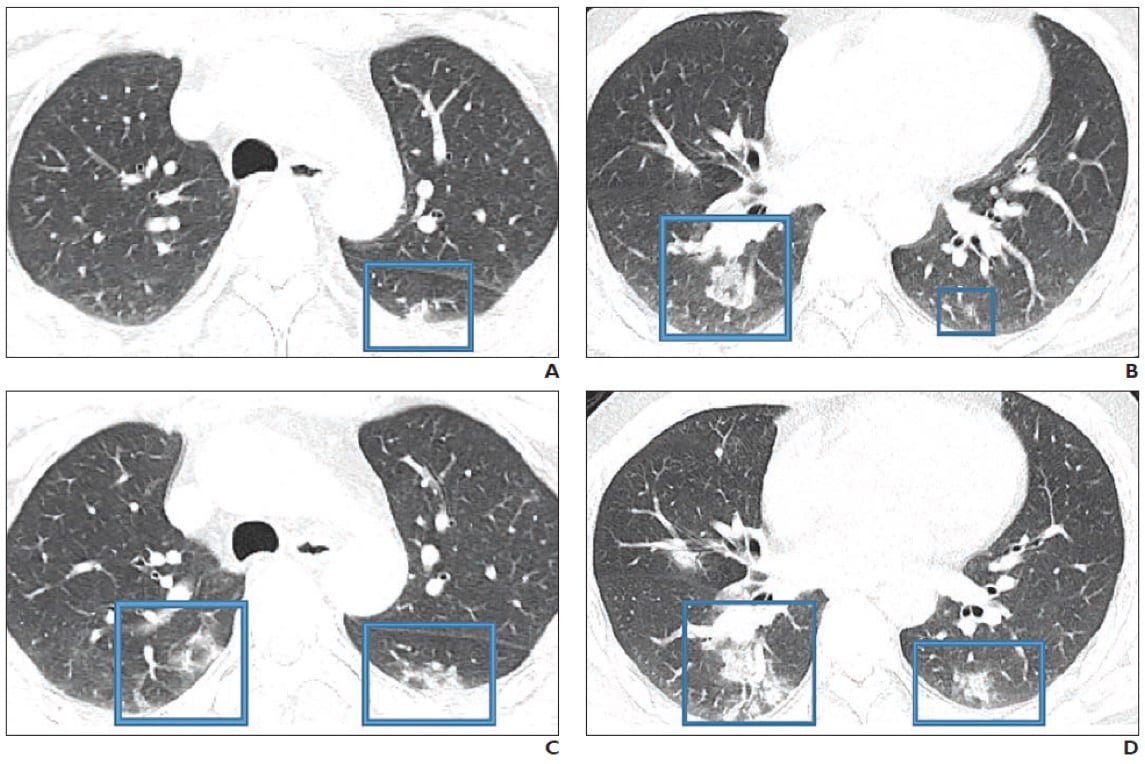

A chest CT scan of a 79-year-old woman who presented with fever, dry cough, and chest pain for three days. Her husband and daughter-in-law had been recently diagnosed with coronavirus disease. The patient expired 11 days after admission.(Courtesy of Song F, Shanghai Public Health Clinical Center, Shanghai, China)
February 28, 2020 — The first in a series of medical imaging studies on novel coronavirus (COVID-19) was published online ahead of print this week by the American Journal of Roentgenology (AJR). The article "Radiology Perspective Of Coronavirus Disease 2019 (COVID-19): Lessons From Severe Acute Respiratory Syndrome And Middle East Respiratory Syndrome," shows that despite COVID-19’s imaging features are variable and nonspecific, the findings reported thus far do show “significant overlap” with those of severe acute respiratory syndrome (SARS) and Middle East respiratory syndrome (MERS).[1]
The article was based on a review of the present clinical literature concerning COVID-19. Unlike SARS and MERS, where initial chest imaging abnormalities are more frequently unilateral, COVID-19 is more likely to involve both lungs on initial imaging.
“Early evidence suggests that initial chest imaging will show abnormality in at least 85 percent of patients, with 75 percent of patients having bilateral lung involvement initially that most often manifests as sub-pleural and peripheral areas of ground-glass opacity and consolidation,” said lead study author Melina Hosseiny, M.D., a University of California at Los Angeles (UCLA) radiologist. She added older age and progressive consolidation may also imply an overall poorer prognosis.
A 47-year-old Chinese man with two-day history of fever, chills, productive cough, sneezing, and fatigue who presented to emergency department. A and B, Initial CT images obtained show small round areas of mixed ground-glass opacity and consolidation (rectangles) at level of aortic arch (A) and ventricles (B) in right and left lower lobe posterior zones. C and D, Follow-up CT images obtained 2 days later show progression of abnormalities (rectangles) at level of aortic arch (C) and ventricles (D), which now involve right upper and right and left lower lobe posterior zones. Image courtesy of AJR.
Since the outbreak of the novel coronavirus in China, more than 82,000 people have contracted the virus and killed 2,800 worldwide.[2] The virus is rapidly spreading with human-to-human transmission despite imposed precautions. Because similar pulmonary syndromes have been reported from other strains of the coronavirus family, the researchers for this study wanted to review the lessons from previous SARS and MERS imaging studies.
COVID-19 is diagnosed on the presence of pneumonia symptoms (including dry cough, fatigue, myalgia, fever and dyspnea), as well as recent travel to China or known exposure, and chest imaging plays a vital role in both assessment of disease extent and follow-up. Unlike SARS and MERS — where initial chest imaging abnormalities are more frequently unilateral — COVID-19 is more likely to involve both lungs on initial computed tomography (CT) imaging.
“To our knowledge,” the study authors wrote, "pleural effusion, cavitation, pulmonary nodules and lymphadenopathy have not been reported in patients with COVID-19.” Ultimately, the authors of this AJR article recommended CT for follow-up in patients recovering from COVID-19 to evaluate long-term or even permanent pulmonary damage, including fibrosis — as seen in SARS and MERS infections.

A comparison of clinical and radiologic features of SARS, MERS and COVID-19 CT imaging from the article in AJR.
Related Coronavirus Content:
CT Provides Best Diagnosis for Novel Coronavirus (COVID-19)
Emerging Technologies Proving Value in Chinese Coronavirus Fight
The Cardiac Implications of Novel Coronavirus
Radiologists Describe Coronavirus CT Imaging Features
Coronavirus Update from the FDA
CT Imaging of the 2019 Novel Coronavirus (2019-nCoV) Pneumonia
Infervision in the Frontlines Against the Coronavirus
CT Imaging Features of 2019 Novel Coronavirus (2019-nCoV)
Chest CT Findings of Patients Infected With Novel Coronavirus 2019-nCoV Pneumonia
Find more related clinical content Coronavirus (COVID-19)
FDA Resource on the Novel coronavirus (COVID-19)
Mount Sinai Physicians the First in U.S. Analyzing Lung Disease in Coronavirus Patients from China
References:
March 09, 2026 